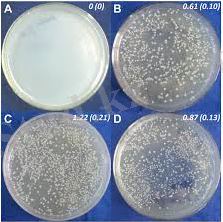
https://encrypted-tbn3.gstatic.com/images?q=tbn:ANd9GcTtXUDaIAe2ej30usQVN3u1wOXV6pWsYUjjXGvFfa0Hs3KT35rnYA

Қойдың брадзоты (секіртпе): клиникасы, патологиялық-анатомиясы және алдын алу


ҚАЗАҚСТАН РЕСПУБЛИКАСЫНЫҢ БІЛІМ ЖӘНЕ ҒЫЛЫМ МИНИСТРЛІГІ
СЕМЕЙ ҚАЛАСЫНЫҢ ШӘКӘРІМ АТЫНДАҒЫ МЕМЛЕКЕТТІК УНИВЕРСИТЕТІ
АГРАРЛЫҚ ФАКУЛЬТЕТ.
«Ветеринариялық медицина» кафедрасы
Курстық жұмыс
Пән: Жануарлардың патологиялық анатомиясы
Тақырыбы: Қойдың брадзоты
Орындаған: Дулатов Е. Ж.
Тексерген: Нуркенова М. К. Топтың студенті: ВМ - 803
(қолы) (қолы)
(өткізген күні) (бағасы) (күні)
Семей -2016
Курстық жұмыстың жоспары.
I. Өлексені сою барысында жазылатын хаттама:
- Хаттама.
А) тіркеу
Б) қысқаша анамнез
2 . Сипаттау бөлімі.
А) өлексенің сыртқы көріністері
Б) өлексенің ішкі көріністері
3 . Қорытынды бөлім.
А) паталогиялық анатомиялық диагноз
Б) лабораториялық зерттеулер нәтижесі
В) өлім себебі туралы қорытынды
II. Анықталған ауруды талдау:
- Аурудың қысқаша анықтамасы және таралуы
- Этиологиясы
- Патогенезі
- Патологияляқ анатомиялық өзгерістер
- Бактериологиялық зерттеулер
- Диагноз
- Диференциальды диагноз
- Қолданылған әдебиеттер тізімі
I. 1. Хаттама.
Тіркеу.
Мал иесі : Атаханов Сайлаубек
Қойдың қайтыс болу уақыты : 22. 11. 2016. сағат 9. 00-де
Мәйітті зертханаға әкелу уақыты : 22. 11. 2016 Сағат 10. 45
Мәйітті сою уақыты : 252. 11. 2016. 11. 30-да
Сою орны : Аудандық ветеринариялық зертхана.
Мәйітті союға қатысқан адамдар : Мұқанов аудандық ветеринарлық инспекциясының маманы. А. зертхана дәрігері Едельбаева А. көмекшісі Андержанова т. зертханашы Атаханова н. с,
Мәйіт туралы мәлімет: Еділбай, 2 жаста, 1 рет Қозылаған.
Қойдың өлім белгілері: ешқандай белгілер байқалмады. Жайылымнан, ол кешке келгенде, жемнен бас тартты. Шамамен таңға шатқаяқтап, аузына тамақ, тәбет болмай, құлап жатыр. Қысқаша анемнез: оның дене қызуы көтеріледі. Мал тынышсызданбаған. Мен Жемге 1 күн қарамадым. Тыныс алу, импульс жиілейді. ауызбен және танаудан көбік аққан. Жиі зәр шығару Іші құрғақ, тістері бұлдыр. Бір сәтте қой тынышталып, орнына секіріп, құлады.
Өлім белгісі: өнімділіғі орташа, оралған жүн.
I. 2. сипаттама бөлігі
Мәйіттің сыртқы көріністері: сыртқы көріністері: қой оң жағында жатыр. Аяқтар созылған. Басы артқа лақтырылады. Конфигурация қалыпты. Душқа арналған гель набухла. Түгі ұшпаған, ауалы. Мұрын мен ауыз қуысынан көпіршікті - қанды сұйықтық ағарып, қолтық пен қолтықтың астынан ісік қан кетті, ісіктің ортасы сұр түске айналды, кесіле бастады, кілегейлі қанаттар қан кетті. Жартылай ашық көзі. Біз көздің конъюнктивасының көгергенін байқадық.

Ішкі көріністер:
1. ауыздың ішкі серозды қабығы қанды бозғылт, қызарған, сәл ісінген. . Егер сіз тілге назар аударатын болсаңыз, онда тістерде іздер қалды.
2. мұрын қуысындағы микро-қан тамырлары шахтасында мукоидоз, содан кейін фибриноидоз дамиды.
3. трахея мен бронхтың шырышты қабаттарында шашыраңқы және жолақты қан кетулер көрінді. Трахеяның ішінде қатпарлар сүйектермен толтырылған. Олардың қан тамырлары тарылған. Түстер өзгермейді. Ісіну байқалмайды. Кремді қабықтарда шашыраңқы қан кетулер көрінді.
4. өкпе . Кеуде және іш қуыстарында қан сарысуы бар, өкпеде-жергілікті ісіну, іш қуысы қанға толы.
5. жүрек сөмкесі сұйықтыққа толы, бұл жүректің көлемін арттырады. Перикард, эпикардийде нүктелік қан кетулер бар. Бұлшықеттерде бұлшықет талшықтарының бөліктері бар ісіну бар. У эндокард кровяные ұйыған, қабырға шероховатые. Қарыншалардың қабырғалары арасында қан ұйығышының болуына байланысты қатынас қалыптыдан ауытқып кетті.
6. диафрагмада кішкентай қан кетулер болды. Қызғылт сары. Онда бұлшықет талшықтары айқын көрінді.
7. Ішектің шырышты қабығына келетін болсақ: он екі елі ішектің шырышты қабығында нүктелі қан кетулер, қан түйіндері орналасқан. Тік ішекте карбункулалар табылды. Ащы ішектің шырышты қабаты жергілікті, кейде қан кетеді. Тоқ ішекте өзгерістер байқалмайды, онда газ тез жиналады.
8. . Бауыр паренхималық күйде, сарғыш түсті, тығыз консистенциялы, жолақты сұр түстің өлі ошақтарымен жабылған. - Мен білмеймін, - деді ол. Кремді қабықтарда нүктелі қан кетулер бар.
9. бүйрек босаңсыған, консистенциясы бұлтты, жергілікті, қан кернеулі. Қоректік және майлы шөгінділердің дистрофиясына тән өзгерістер анықталды және көкнәр эмбрионындағыдай шашыраңқы және тығыз орналасқан сұр түсті өлі ошақтар көрінеді.
10. талақ көлемді ісінген және ішектер қанға толы. Целлюлоза кофе алаңдары сияқты ағып кетті. Егер сіз сау жануарлардың көкбауырымен салыстырсаңыз, онда айтарлықтай айырмашылық байқалмады. Яғни көлемі бойынша.
11. тері мен қабықтың қабаты . Ауа-райының терісінің ішкі жағы қоңыр-қызыл, шелектегі қан тамырлары қан кетеді, әр жерде қанды жабын пайда болады. Әр жерде нүктелі қан кету болды. Шап лимфа түйіндері үлкейген, Сулы, қан кетеді.
12. қан қоңыр-қоңыр, қалыңдатылған, барлық мүшелерде қан кету байқалады, қан кету кезінде олардағы қан қара қоңырға айналады.
13. бұлшықеттердің түсі өзгермейді деп айта аламыз. Бұлшықет талшықтары айқын көрінеді.
14. Егер сіз жыныстық жүйеге назар аударатын болсаңыз, онда қуықтың мембраналарында сұйықтық жинақталған. Бірақ үзіліс болған жоқ. Қынап пен қынапқа кіру қызарған. Ісіктер байқалады. Ісік беті құрғақ.
15. сүйектер қалыпта тұрды, сүйектерде құрғақтық байқалады.
16. буындардағы ісіктер. Ei ққп есебінен алдыңғы және артқы аяқтарда кездеседі. Көгеру нәтижесінде артикулярлы беттер зақымдалады.
I. 3. Қорытынды бөлім:
Патологиялық анатомиялық диагноз:
Бастың, мойынның, кеуденің және кейде дененің басқа бөліктерінің тері астындағы тіндері қан сары, газ көпіршіктерімен қаныққан. Бұлшықеттер өзгермейді. - Мен білмеймін, - деп жауап берді ол. Көрінетін кремді қақпақтар көкшіл. Шеттері қан тамырларында қан кетпейді. Трахея мен бронхтың шырышты қабаттарында шашыраңқы және жолақты қан кетулер болады. Ішіндегі кеңірдек жасалынады складчатыми сүйектері. Алдыңғы ішектер жынға толы, он екі елі ішек бос, диафрагма мен плеврада ұсақ қан кетулер болды. Кеуде және іш қуысында қан сарысуы бар, өкпесі қанға толы. Жүрек қанындағы сұйықтық мол болады. Эпикард пен эндокард қан кетеді, ал жүрек босаңсытады. Көкбауыр аздап артады. Бауыр қанға толы, бетінде өлі еттің ошақтары бар, олар кесілгеннен гөрі сұрғылт түсті көрінеді. Бүйрек босаңсыған, босаңсыған, қан кернеулі. Ащы ішектің шырышты қабаты қан кетеді және қан кетеді. Тоқ ішекте өзгерістер байқалмайды, онда газ жиналады.
Лабораториялық зерттеулер нәтижесі:
Зертханаға мәйіттер немесе жеке мүшелер жіберіледі: бүйрек, көкбауыр, бауыр бөлімі, түйежапырақ зақымдалған жерлер, түйежапырақ ішектері, сүйек сүйегі, тері астындағы тін. Зертханада микроскопия жүргізеді, таза өсуді алады және ақ тінтуір мен теңіз тінтуіріне биосынама мен бейтараптандыру реакциясын қояды. Бактериологиялық зерттеуге арналған материалды жаңа ғана өлген немесе ұшасы кезінде пышаққа ілінген жануарлардан алады. Микроскопия кезінде жағынды негізгі фуксин ерітіндісімен және грам әдісімен боялады. Clostridium septicum микробтың бауырға тиген әйнекте жіп тәрізді үзік-үзік тізбек түрінде орналасуымен сипатталады. Барлық материалдардан, әсіресе тері астындағы жалқаулықтан, пюре сорпасына, қанды агарға егіліп, ауа баға жетпес жағдайда өсіріледі. Сұйық ортада микробтың өсуі 24 сағат, ал тығыз ортада 24-48 сағат тексереді. Бөлінген таза өсу кезінде зертханалық жануарлар жұқтырады, әсіресе теңіз тышқанында учаскенің патологиялық-анатомиялық өзгерістері байқалады. Микробтың түрі өсу және морфологиялық қасиеттері бойынша сенімді. Өлім себебі туралы қорытынды:
Мал күйзеліп, жем- шөпке қарамайды. Тынысы, тамыр соғысы жиілеп, ауызы мен тануынан көбік ағады. Кейде қан аралас іші өтіп, несеп шығаруы жиілейді, іші кеуіп, тісін шықырлатады. Кейбір ауырған қой тынышсызданып бір орында секіріп құлаған. Содан өлімше ұшыраған.

II. Анықталған ауруды талдау.
1. Аурудың анықтамасы.
Қойдың брадзоты немесе секіртпе (Bradzot, қойдың брадзоты) - он екі елі ішектің және ішкі ағзалардың шырышты қабығынан қан кетумен сипатталатын өткір, төзбейтін жұқпалы ауру.
Тарихи деректер . Бұл ауру туралы алғашқы жазба өткен ғасырдың ортасында Солтүстік Еуропа елдерінде (Исландия, Дания, Норвегия, Шотландия) жарық көрді. 1875 жылы Краббе тәуелсіз ауру ретінде сипатталды. Тек 1920 жылы бұл инфекциялар" некрозды гепатит" деп аталды, оның қоздырғышы Cl болды, ол" қара ауруды "" брадзот тәрізді ауру", " неміс брадзоты", " некрозды гепатит"деп аталатын басқа аурулардан ажыратпады. gigas (Cl. novyi түрі) . Бұл микроб қазірдің өзінде қосымша брадзот стимуляторы ретінде қабылданады. Брадзоттың қоздырғышын алғаш рет 1874 жылы патер мен Джаббер сипаттаған, таза осьті 1888 жылы и. Нильсон және 1892 жылы Арлуэн бөлген.
... жалғасы

Аурудың қоздырғышы. Брадзоттың негізгі қоздырғышы-Clostridium septicum-полиморфты, грам-позитивті, қозғалмалы үлкен таяқша, қабығы жоқ, споралары перифериялық орналасқан. Құлаған малдың бауырынан алынған жағындыда ұзын тізбек пайда болады. Анаэробты микробтар үшін барлық ортада жақсы өседі. Китта - Тароцци сорпасында өте тез өседі, 16-24 сағат. қоректік орта бұлтты болады және газ шығады, 48 сағат өткен кезде микробтар түтіктің түбіне түсіп, соргпа тұндырылады. Clostridium septicum күрделі құрамы бар ерекше күшті экзотоксинді шығарады. Токсинді Мартен сорпасындағы көшеттерден сүзуге болады. Бұл улы зат альфа, бетта, гамма және дельта токсиндері деп аталады. Олардың әрқайсысының өзіне тән уытты қасиеті бар. Сонымен қатар, фибринолизин мен коллагеназа тіндерде кездеседі және гангрена болған кезде тіндердің зақымдалуына әкеледі. Патогеннің құрамында О-және Н-антиген бар. Олар әртүрлі антиденелердің пайда болуына иммуногендік әсер етеді.
Брадзоттың негізгі қоздырғышы да, онымен бірге жүретін басқа клостридиялар да сыртқы ортадағы химиялық және физикалық әсерлерге төзімді. Олар топырақта көптеген жылдар бойы сақталады және тиісті жағдайлар болған кезде өніп шығады. Қайнаған кезде ол 60 минут ішінде өледі.
Дезинфекция үшін 3% хлормен тұндырылған ағартқыш ерітінді, 10% күкірт-карбол қоспасының ыстық ерітіндісі, 5% каустикалық натрий ерітіндісі, 10% формальдегид ерітіндісі қолданылады.
Эпидемиялық ерекшеліктері. Ешкі қойдан басқа үй жануарларынан секіреді. Ауру өте жіті түрінде немесе жіті індет ретінде байқалады. Табиғи жағдайда қойлар жынысына және жасына қарамастан ауырады, көбінесе екі жасқа дейінгі жануарлар ауырады, әдетте семіздіктің жоғарылауы байқалады. Кейде тек жас қойлар ауырады, кейде тек ересек қойлар ауырады. Ауру жылдың кез келген маусымында пайда болуы мүмкін. Бірақ көбінесе бұл қыста немесе құрғақ жаз айларында байқалады.
Қоздырғыштың басталуы-ауру қой. Өлген қойлардың мәйіттері жайылым мен суды брадзот қоздырғышымен ластайды. Ауру алиментарлық жолмен және су арқылы беріледі.
Дерттенуі. Секірулер кезінде патологиялық процестің даму заңдылықтары толық анықталмаған. Аурудың қоздырғышын алиментарлы жолмен беру кезінде, тіпті көп мөлшерде болса да, брадзот байқалмайды. Парентеральды инфекциямен жануардың аурудың тән клиникалық белгілері жоқ. Аурудың пайда болуында жануарлар денесінің табиғи төзімділігі маңызды рөл атқарады. Стресс факторларына (ыстық, суық, ішек) ұшыраған кезде дененің кедергісі нашарлайды, ішектің қозғалғыштығы бұзылады, қоздырғыштың тез өсуіне жағдай жасалады. Нәтижесінде ағзаны уландыратын және өлімге әкелетін экзотоксиндердің көп мөлшері шығарылады.
Өтуі мен белгілері. Секіртпе аса жіті және жіті өтеді. Аса жіті өткенде жасырын кезеңі бірер сағат қана, ал жіті өткенде бір тәулікке дейін созылады.
Аса жіті өткенде мал кенеттен өліп кетеді. Алдында ғана сау жүрген қой кенеттен тыпыршып, бір орында секіріп барып құлайды. Осындай ерекше жәйт аурудың халық арасында "секіртпе" деп аталуына себеп болған. Жығылған қойдың ауызынан көбік ағып, тісін шықырлатып, бірер минутта өліп кетеді. Кешкісін сау малдың таңертең өлексесі жатады.

Секіртпе жіті откенде дененің ыстығы көтеріліп, мал күйзеліп, жем- шөпке қарамайды. Тынысы, тамыр соғысы жиілеп, ауызы мен тануынан көбік ағады. Кейде қан аралас іші өтіп, несеп шығаруы жиілейді, іші кеуіп, тісін шықырлатады. Кейбір ауырған қой тынышсызданып бір орында секіріп немесе айналшықтап, жер тарпиды, оқтын-оқтын құрыстанады.

Тынышсызданудан соң дел-сал күйге ауысады да, жатып қалады. Жатқанда аяқтарын созып, мойынын артқа немесе бір жағына қарай бұрады. Ауырған мал демігіп, әлсіреп барып, бір күнге жетпей өледі. Ауру бәсеңдеу өткенде 3-5 күнге дейін созылып, өліммен аяқталады.
Патологиялық өзгерістер. Секіруден қайтыс болған қойдың мәйіті бірнеше сағат бойы газға ұшырап, терісі тез көгеріп кетті. Жағымсыз иіс шығады, ал қанды көбік оның табиғи тесіктерінен ағып кетеді.
Бастың, мойынның, кеуденің және кейде дененің басқа бөліктерінің тері астындағы тіндері қан сары, газ көпіршіктерімен қаныққан.
Бұлшықеттер өзгермейді. Көрінетін кілегейлі қабықтар көкшіл түсті . Шеттері қан тамырларында қан кетпейді. Трахея мен бронхтың шырышты қабаттарында шашыраңқы және жолақты қан кетулер болады. Ішіндегі кеңірдек жасалынады складчатыми сүйектері. Алдыңғы ішектер жынға толы, он екі елі ішек бос, диафрагма мен плеврада ұсақ қан кетулер болды. Кеуде және іш қуысында қан сарысуы бар, өкпесі қанға толы. Жүрек қанындағы сұйықтық мол болады. Эпикард пен эндокард қан кетеді, ал жүрек босаңсытады. Көкбауыр аздап артады. Бауыр қанға толы, бетінде өлі еттің ошақтары бар, олар кесілгеннен гөрі сұрғылт түсті көрінеді. Бүйрек босаңсыған, босаңсыған, қан кернеулі. Ащы ішектің шырышты қабаты қан кетеді және қан кетеді. Тоқ ішекте өзгерістер байқалмайды, онда газ жиналады.
Балау. Секіртпе диагнозы эпизоотологиялық деректерді, клиникалық белгілерді, патологоанатомиялық өзгерістерді ескере отырып және зертханалық зерттеулердің нәтижелері бойынша қойылады. Зертханаға мәйіттер немесе жеке мүшелер жіберіледі: бүйрек, көкбауыр, бауыр бөлімі, түйежапырақ зақымдалған жерлер, түйежапырақ ішектері, сүйек сүйегі, тері астындағы тін. Зертханада микроскопия жүргізеді, таза өсуді алады және ақ тінтуір мен теңіз тінтуіріне биосынама мен бейтараптандыру реакциясын қояды. Бактериологиялық зерттеуге арналған материалды жаңа ғана өлген немесе ұшасы кезінде пышаққа ілінген жануарлардан алады. Микроскопия кезінде жағынды негізгі фуксин ерітіндісімен және грам әдісімен боялады. Clostridium septicum микробтың бауырға тиген әйнекте жіп тәрізді үзік-үзік тізбек түрінде орналасуымен сипатталады.
Барлық материалдардан, әсіресе, міндетті түрде тері астындағы жалқақтан етпептон сорпасына, қанды агарға егіп, ауасы бағасыз жағдайда өсіреді. Сұйық ортада микробтың өсуін 24 сағ., ал тығыз ортада 24-48 сағ. тексереді. Бөлінген таза өсінмен лабораториялық жануарларды жұқтырады, әсіресе, телімді патологиялық-анатомиялық өзгерістер теңіз тышқанында байқалады. Микробтың түрін өсіндік және морфологиялық қасиеттері бойынша анық- тайды.
Ажыратып балау . Брадзотты, жұқпалы энтеротоксемия, пастереллез, карасан, пироплазмоз және қорғасын шөптерімен уланудан ажырату керек.
Топалаң кезінде көкбауыр өсіп, жұмсарып, кірпіш массасына айналады. Микроскопиямен аурудың қоздырғышы көрінеді.
Егер ересек үй қояны карасанды ажырату үшін жұқтырса, ол секіргіш қоздырғышқа сезімтал болады және карасан қоздырғышына төзімді болады. Инфекциялық энтеротоксемияда бүйрек жеткіліксіздігі, бауырдың зақымдануы, он екі елі ішектің шырышты қабығының қабынуы байқалмайды. Сонымен қатар, мәйіттер тез нашарлайды, тері астындағы тіндерде қан кететін Сарысу болмайды. Энтеротоксемиядан бактериологиялық тексеру арқылы бөлінеді. Пастереллезбен жоғарғы тыныс алу мүшелеріне әсер етеді, зақымдайды. Ауруды анықтау үшін бактериологиялық зерттеу жүргізіледі.
У Қорғасынмен уланған кезде ішектің серозды мембраналары жаппай қан кетеді. Жайылымды улы Шөпке қарайды, токсикологиялық зерттеу жүргізеді.
- Іс жүргізу
- Автоматтандыру, Техника
- Алғашқы әскери дайындық
- Астрономия
- Ауыл шаруашылығы
- Банк ісі
- Бизнесті бағалау
- Биология
- Бухгалтерлік іс
- Валеология
- Ветеринария
- География
- Геология, Геофизика, Геодезия
- Дін
- Ет, сүт, шарап өнімдері
- Жалпы тарих
- Жер кадастрі, Жылжымайтын мүлік
- Журналистика
- Информатика
- Кеден ісі
- Маркетинг
- Математика, Геометрия
- Медицина
- Мемлекеттік басқару
- Менеджмент
- Мұнай, Газ
- Мұрағат ісі
- Мәдениеттану
- ОБЖ (Основы безопасности жизнедеятельности)
- Педагогика
- Полиграфия
- Психология
- Салық
- Саясаттану
- Сақтандыру
- Сертификаттау, стандарттау
- Социология, Демография
- Спорт
- Статистика
- Тілтану, Филология
- Тарихи тұлғалар
- Тау-кен ісі
- Транспорт
- Туризм
- Физика
- Философия
- Халықаралық қатынастар
- Химия
- Экология, Қоршаған ортаны қорғау
- Экономика
- Экономикалық география
- Электротехника
- Қазақстан тарихы
- Қаржы
- Құрылыс
- Құқық, Криминалистика
- Әдебиет
- Өнер, музыка
- Өнеркәсіп, Өндіріс
Қазақ тілінде жазылған рефераттар, курстық жұмыстар, дипломдық жұмыстар бойынша біздің қор #1 болып табылады.



Ақпарат
Қосымша
Email: info@stud.kz